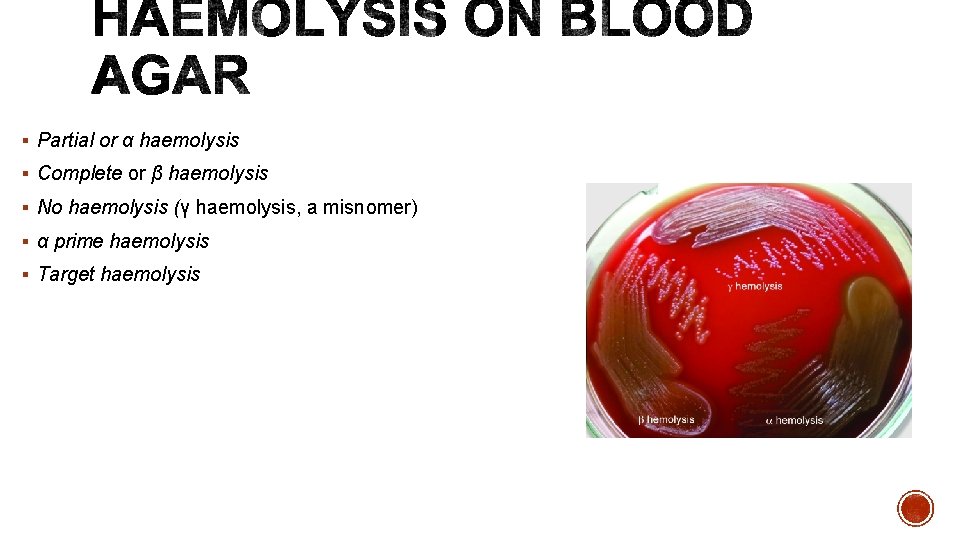
§ Partial or α haemolysis § Complete or β haemolysis § No haemolysis (γ

STAINING TECHNIQUES BIOCHEMICAL REACTIONS ANTIBIOTIC SUSCEPTIBILITY TESTING Dr

STAINING TECHNIQUES BIOCHEMICAL REACTIONS ANTIBIOTIC SUSCEPTIBILITY TESTING Dr. Mohit Bhatia Assistant Professor Department of Microbiology AIIMS, Rishikesh


§ Smear = 2 × 3 cm in size. § Smear should neither be too thick nor too thin - When placed over a printed matter, the print should be readable through the smear. § The smear is air dried for 15– 30 minutes and then heat fixed by passing over the flame 3– 5 times for 3– 4 seconds. *during smear preparation. Smear preparation should be done near a flame as six inches around the flame is considered sterile zone as it coagulates the aerosol raised

§ There are two types of fixation: o Heat fixation: Gentle flame heating an air-dried film of bacteria. o Chemical fixation: Done using ethanol, acetic acid, mercuric chloride, formaldehyde, methanol and glutaraldehyde. Useful for examination of blood smears.


Simple stain: Basic dyes (methylene blue or basic fuchsin) are used to provide the color contrast, but imparts the same color to all the bacteria in a smear. Negative staining: A drop of bacterial suspension is mixed with dyes (India ink or Nigrosin). The background gets stained black where as unstained bacterial/yeast capsule stand out in contrast. Impregnation methods: Bacterial cells and structures are thickened by impregnation of silver salts on their surface to make them visible, e. g. for demonstration of bacterial flagella and spirochetes

§ Differential stain: Two stains are used which impart different colors to different bacteria or bacterial structures, which help in differentiating bacteria. Most commonly employed differential stains are: 1. 2. 3. Gram stain: Differentiates bacteria into gram-positive and gram-negative groups. Acid-fast stain: Differentiates bacteria into acid fast and non acid-fast groups. Albert stain: differentiates bacteria having metachromatic granules from other bacteria that do not have them.

§ Originally developed by Hans Christian Gram (1884). § Gram stain still remains the most widely used test in diagnostic bacteriology.

§ Gram-positive bacteria resist decolorization and retain the color of primary stain i. e. violet. § Gram-negative bacteria are decolorized and, therefore, take counterstain and appear pink.

Theory Explanation p. H theory • Cytoplasm of Gram-positive bacteria is more acidic - retains the basic dye (e. g. crystal violet) for longer time. • Iodine serves as mordant – combines with the primary stain to form a dye-iodine complex which gets retained inside the cell

Theory Explanation Cell wall theory • Gram-positive cell wall has a thick peptidoglycan layer (50– 100 layers thick), act as a permeability barrier preventing loss of crystal violet and alcohol is thought to shrink the pores of the thick peptidoglycan. • Gram-negative cell wall o More permeable thus allowing the out flow of crystal violet easily attributed to thin peptidoglycan layer. o Presence of lipopolysaccharide layer in the disrupted by the action of acetone or alcohol. o Mordanting with Gram’s iodine, bigger dye iodine complexes are formed in the cytoplasm. o Following decolorization, as more lipid content in gram-negative bacterial cell wall gets dissolved leading to formation of larger pores.

Modifications Explanation Kopeloff and Beerman’s Primary stain - Methyl violet Counter stain - Basic fuchsin Jensen’s Absolute alcohol as decolorizer and neutral red as counter stain. Useful for meningococci and gonococci Weigert’s Aniline-xylol is used as a decolorizer. Useful for staining tissue sections Preston and Morrell’s Iodine-acetone is used as decolorizer.

1. Identification of Gram-positive and Gram-negative. 2. For identification of Gram staining from bacterial culture helps in further identification of bacteria 3. Helps in initiation of empirical treatment with broad spectrum antibiotics can be started early before the culture report is available. 4. Gram stain helps in early presumptive identification of fastidious organisms, such as Haemophilus. 5. Gram stain gives a preliminary clue in anaerobic culture (Clostridium). 6. Helps in identification of Candida and Cryptococcus spp.

§ Discovered by Paul Ehrlich and subsequently modified by Ziehl and Neelsen. § Acid fastness is due to presence of mycolic acid in the cell wall. Acid fast organisms /structures Sulphuric acid (%) needed for decolorization 25% 5% 1% 1% Mycobacterium tuberculosis Mycobacterium leprae Nocardia spp. Acid fast parasites such as Cryptosporidium , Cyclospora, Cystoisosopra, Microsporidia, Taenia saginata segments and hooklets of hydatid cyst Bacterial spore 0. 25 -0. 5% Sperm head 0. 5 -1% Legionella micdadei 0. 5 -1%

§ Step 1 (primary stain) - Carbol fuchsin (1%) for 5 minutes. Intermittent heating is done by flaming until the vaporize. § Step 2 (decolorization) - 25% sulfuric acid for 2– 4 minutes. § Step 3 (counter staining) - 0. 1% methylene blue slide for 30 seconds.

§ Mycobacterium tuberculosis appears as long slender, straight or slightly curved and beaded, red colored acid fast bacillus.

Cold method (Kinyoun’s method): Intermittent heating is not required. Ø Acid-alcohol can be used as decolorizer alternatively. Ø Malachite green can be used as counter stain. Ø

§ Used to demonstrate the metachromatic granules of Corynebacterium diphtheriae. Interpretation § Corynebacterium diphtheriae appears as green colored bacilli. Corynebacterium xerosis and Gardnerella vaginalis also possess metachromatic granules.

1. Unstained (Wet) Preparations 2. Vital stains - For differentiating the living cells from dead cells. o Viability can be assessed by counting the percentage of total cells that do not take up the stain. * Examples of vital stains - eosin, propidium iodide, trypan blue, erythrosine and neutral red.

Bacteria Cluster Example Gram positive cocci arranged in Staphylococcus Chain Streptococcus Pairs, lanceolate shaped Pneumococcus Pair or in short chain, spectacle eyed shape Tetrads Enterococcus Octate Sarcina Micrococcus Gram negative cocci arranged in Pairs, lens shaped Meningococcus Pairs, kidney shaped Gonococcus

Bacteria Example Gram positive bacilli arranged in Chain(bamboo stick Bacillus anthracis appearance) Chain Streptobacillus Chinese letter or cuneiform Corynebacterium pattern diphtheriae Palisade pattern Diphtheroids Branched and filamentous form Actinomyces and Nocardia Bacteria Example Gram negative bacilli arranged in Pleomorphic (various shapes) Haemophilus, Proteus Thumb print appearance Bordetella pertussis Comma shaped (fish in stream appearance) Curved Spirally coiled, flexible Rigid spiral forms Bacteria that lack cell wall Vibrio cholerae Campylobacter (Gullwing shaped) and Helicobacter Spirochetes Spirillum Mycoplasma



§ Direct demonstration of flagella o Tannic acid staining(Leifson’s method & Ryu’s method) o Dark ground, phase contrast or electron microscope § Indirect means by demonstrating the motility: o Cragie tube method o Hanging drop method o Semisolid medium- e. g. mannitol motility medium


Types of motility Bacteria shown Tumbling motility Gliding motility Stately motility Darting motility Listeria Mycoplasma Clostridium Vibrio cholerae, Campylobacter Proteus, Clostridium tetani Spirochaete Swarming motility Corkscrew, lashing, flexion extension motility



§ Direct Microscopy- o Direct smear examination- Specimens are subjected to the following staining techniques. o Gram staining o Albert's staining o Ziehl-Neelsen (ZN) acid fast staining

§ Depending on the type of specimen, various culture media are used. § Combination of blood agar and Mac. Conkey agar is most commonly employed for most specimens.

§ Combination of blood agar and Mac. Conkey agar - pus, wound swab &other exudate specimens, sterile body fluids, urine, sputum and other respiratory specimens. § Chocolate agar - Respiratory and sterile body fluid specimens. § Stool specimen should be inoculated on to selective media such as- o Mildly selective media-Mac. Conkey agar and o Highly selective media-DCA, XLD and TCBS § Blood specimen should be directly inoculated into blood culture bottles without performing direct microscopy methods. § CLED agar - urine specimen

§ Size-in millimetres e. g. pin head size is characteristic of staphylococcal colony & pin point size is characteristic of streptococci colony § Shape – Circular or irregular § Surface –glistening or dull § Edge-Entire, crenated, lobate, undulated or filamentous § Elevation-flat, raised, convex, umbonate, or pulvinate § Consistency - Mucoid, friable, firm, butyrous § Density–opaque, translucent or transparent

§ Colour of the colony- Colonies may be coloured due to properties of the media used or due to pigment production. § Pigment produced by certain bacteria may also colour the colony. Pigments are of two types. o Diffusible pigments o Non-diffusible pigments
§ Partial or α haemolysis § Complete or β haemolysis § No haemolysis (γ haemolysis, a misnomer) § α prime haemolysis § Target haemolysis

§ Colonies grown on the culture media should be subjected to Gram staining and motility testing by hanging drop method.

§ Based on the type of organisms detected in culture smear, the appropriate biochemical tests are employed. § Catalase and oxidase tests § For Gram negative bacilli- Common biochemical tests done routinely areo Indole test o Citrate utilization test o Urea hydrolysis test o Triple sugar iron test (TSI)

§ If there is any doubt in correct identification of bacteria, then further biochemical tests are put such as- o Sugar fermentation test o MR (methyl red) test o VP (Voges Proskauer) test o OF test (oxidation –fermentation test) o Nitrate reduction test o Decarboxylase test o PPA test (phenyl pyruvic acid test)

§ Coagulase test (for Staphylococcus aureus) § DNase test (for Staphylococcus aureus) § CAMP (Christie Atkins Munch-Petersen) test for Group B Streptococcus. § Bile esculin hydrolysis test (for Enterococcus) § Heat tolerance test (for Enterococcus) § Sugar fermentation test § PYR test (for Streptococcus pyogenes and Enterococcus) § Bile solubility test (for pneumococcus)

1. Novobiocin susceptibility test- done for Staphylococcus saprophyticus 2. Optochin susceptibility test (for pneumococcus) 3. Bacitracin susceptibility test-done to differentiate group A and group B Streptococcus)

§ When a drop of hydrogen peroxide (3% H 2 O 2) is added to a colony of any catalase producing bacteria, effervescence or bubbles appear due to breakdown of H 2 O 2 by catalase to produce oxygen.

§ Detects the presence of cytochrome oxidase enzyme in bacteria which catalyses the oxidation of reduced cytochrome by atmospheric oxygen. § Oxidase positive (deep purple)- Examples include Pseudomonas , Vibrio, Neisseria, Bacillus etc. § Oxidase negative (no colour change)-Examples include; members of family Enterobacteriaceae, Stenotrophomonas, etc.

§ Detects the ability of certain bacteria to produce enzyme tryptophanase that breaks down amino acid tryptophan present in the medium into indole. § Indole positive Escherichia coli, Proteus vulgaris, Vibrio cholerae etc. § Indole negative - Examples include- Klebsiella pneumoniae, Proteus mirabilis, Pseudomonas, Shigella, Salmonella, etc.

§ Detects the ability of a few bacteria to utilize citrate as the sole source of carbon for its growth, with production of alkaline metabolic products. § Citrate test is positive for Klebsiella pneumoniae, Citrobacter, Enterobacter etc. § Test is negative for Escherichia coli, Shigella, Salmonella Typhi, etc.

§ Urease producing bacteria can split urea present in the medium to produce ammonia that makes the medium alkaline. § Urease test is positive for-Klebsiella pneumoniae, Proteus species, Helicobacter pylori, Brucella, etc. § Urease negative - Escherichia coli, Shigella, Salmonella, etc.

§ Composition- It is a composite solid agar medium in tube having a butt & a slant. Its constituents include- § Three sugars- glucose, sucrose and lactose in the ratio of 1: 10 parts § Phenol red as an indicator of acid production § Ferric salts as an indicator of hydrogen sulphide (H 2 S).

Interpretation § Ability to ferment sugars to produce acid § Ability to produce gas § Ability to produce H 2 S


Reactions in TSI Acidic slant/acidic butt Examples ≥ 2 sugars fermented • Glucose fermented & • Lactose and/or sucrose fermented Escherichia coli Klebsiella pneumoniae Only glucose fermenter group Shigella A/A, gas produced, no H 2 S (fig 6 B) Alkaline slant/acidic butt K/A, no gas, no H 2 S (fig 6 C) K/A, no gas, H 2 S produced (small amount), fig 6 D K/A, no gas, H 2 S produced (abundant), fig 6 E K/A, gas produced, H 2 S produced (abundant) K/A, gas produced, no H 2 S Alkaline slant/alkaline butt K/K, no gas, no H 2 S (fig 6 F) S. Typhi Proteus vulgaris S. Paratyphi B S. Paratyphi A Non fermenters group Pseudomonas Acinetobacter

§ Detects the ability of an organism to ferment § A specific carbohydrate (sugar) incorporated in a medium producing acid with/without gas. Glucose, lactose, sucrose and mannitol are widely used for sugar fermentation. § Acid production is detected by using indicators such aso Andrade's indicator o Phenol red indicator o Gas production is detected by using an inverted Durham’s tube


§ Detects the presence of substrate specific decarboxylase enzyme in the bacteria that break down amino acids such as lysine, arginine and ornithine to produce alkaline by-products.

§ In glucose phosphate broth, certain bacteria ferment glucose to produce stronger acids that maintain the p. H below 4. 4 which turns methyl red indicator from yellow to red colour o MR Positive (red colour)-Escherichia coli o MR negative(yellow, i. e. no change in colour)- Klebsiella pneumoniae

§ In the presence of alkali and atmospheric oxygen, acetoin is oxidised to diacetyl which reacts with α-naphthol to give red colour § VP positive- Klebsiella pneumoniae, Enterobacter, El Tor vibrios, Staphylococcus, etc. § VP negative - Escherichia coli, Shigella, Salmonella, etc.

Open tube Covered tube Metabolism Acid (yellow) Fermentative bacteria Acid (yellow) Alkaline (green) Oxidative bacteria (i. e. non fermenters) Alkaline (green) Asaccharolytic bacteria

§ Detects the presence of an enzyme nitrate reductase in the organism, which reduces nitrate present in the medium (nitrate broth) to nitrite or free nitrogen gas. § Nitrate test positive- All members of family Enterobacteriaceae.

§ Specific test done for members of tribe Proteae; which includes Proteus, Morganella and Providencia. § They possess a specific enzyme that deaminates phenylalanine present in the medium to phenyl pyruvic acid (PPA). § PPA reacts with few drops of 10% ferric chloride solution to produce green colour.

§ Bacteria exhibit great strain variations in susceptibility to antimicrobial agents – hence it is necessary to determine the susceptibility of pathogenic bacteria isolated from the clinical specimens.

1. Disc diffusion methods- o Kirby-Bauer disc diffusion method o Stokes disc diffusion method 2. Dilution tests- o Broth dilution method o Agar dilution method 3. E-test 4. Automated methods 5. Molecular methods (PCR detecting drug resistant genes)

§ Most widely used method. § Suitable for rapidly growing pathogenic bacteria. § Unsuitable for slow growing bacteria. § This method uses filter paper discs impregnated with appropriate concentration of the antibiotic solution.

§ Test bacterium is inoculated (as lawn culture) on the solid medium and then the antibiotic discs are applied. § The antibiotic in the discs diffuses through the solid medium § Concentration is highest near the site of application of the antibiotic disc and decreases gradually away from it.


o Best medium to use for routine susceptibility testing of non-fastidious bacteria for the following reasons: Ø It shows acceptable batch-to-batch reproducibility for susceptibility testing. Ø It supports satisfactory growth of most non fastidious pathogens. Ø It has minimal inhibitory effect on sulphonamide and trimethoprim. Hence these antibiotics are better tested in MHA than any other media.

§ Modifications of MHAo. Lysed horse blood is added to MHA to support the growth of fastidious organisms such as H. influenzae. o 4% Sodium chloride (Na. Cl) should be added to the medium for testing MRSA isolates.

§ Isolated pure colonies of the test organism are inoculated in a suitable liquid medium (peptone water broth). § Incubated at 35 -37°C for 4 -6 hours. § Density adjusted to 1. 5 X 108 cfu/ ml by comparing its turbidity with that of 0. 5 Mc. Farland opacity standard tube. § Ideal inoculum after overnight incubation gives even semi-confluent growth. Too heavy inoculum reduces the size of inhibition zones.

§ Lawn culture § The following ATCC (American Type Culture Collection) strains are used as standard control strains. o Escherichia coli ATCC 25922 o Pseudomonas aeruginosa ATCC 27853 o Staphylococcus aureus ATCC 25923 o Enterococcus faecalis ATCC 29212

§ Antibiotic discs - 6 mm diameter are impregnated with standard quantity of antibiotic solution. § Choice of antibiotic disc : o Antibiotics should likely to be used for therapy of infections. o Local prescribing habits of the antimicrobial agents. o Resistant pattern of the locally prevalent pathogens o Cost, toxicity, pharmacokinetics, and spectrum of activity of an antimicrobial agent

§ First line drugs o Commonly used for treatment. o Antibiotic currently being administered to the patient. o Spectrum should be relevant to the organism isolated. § Second line drugs o Restricted only to special circumstances. o Reserved for testing later if the organism is found to be resistant to all the first line antibiotics tested before.

§ A cotton swab is dipped into inoculum and squeezed to drain out the excess fluid. § Swab is inoculated on to the Mueller-Hinton agar plate by lawn culture. § After drying the surface of agar plate for 3 -5 minutes -antibiotic discs are applied using either sterile forceps or multidisc dispenser.

§ Plates are incubated at 37°C for 16 -18 hours. § When tested for MRSA, result should be read only after 24 hr of incubation. § Zone size is measured using a ruler or Vernier caliper. § Interpretation of zone size into sensitive, intermediate or resistant is based on the standard zone size interpretation chart.

Antimicrobial agents Benzyl penicillin (S. aureus) Cefoxitin (S. aureus) Gentamicin (G) Amikacin (Ak) Erythromycin (E) Tetracycline (T) Nitrofurantoin (Nf) Ciprofloxacin (Cf) Ceftriaxone (Ci) Imipenem (I) Vancomycin (for enterococcus) Disc strength (µm) 10 units 30 10 30 15 30 300 5 30 10 30 Diameter of zone of inhibition (in mm) Resistant ≤ 28 ≤ 21 ≤ 12 ≤ 14 ≤ 13 ≤ 14 ≤ 15 ≤ 19 ≤ 14 Intermediate 13 -14 15 -16 14 -22 15 -18 15 -16 16 -20 20 -22 15 -16 Sensitive ≥ 29 ≥ 22 ≥ 15 ≥ 17 ≥ 23 ≥ 19 ≥ 17 ≥ 21 ≥ 23 ≥ 17

§ Performed when results are required urgently and single pathogenic bacterium is suspected in the specimen. § Disc diffusion directly performed from a clinical specimen. § Results of the primary test should be subsequently verified.

§MIC (minimum inhibitory concentration) - Lowest concentration of an antimicrobial agent that will inhibit the visible growth of a microorganism after overnight incubation. §Dilution tests: o. Broth dilution o. Agar dilution

§ Serial dilutions of the antimicrobial agent in MH broth § Each tube is inoculated with a fixed amount of suspension of the test organism along with controls. § MIC is determined by noting the lowest concentration of the drug at which there is no visible growth.

Broth Dilution § The minimum bactericidal concentration (MBC) can be obtained by sub culturing from each tube (showing no growth) onto a nutrient agar plate without any antimicrobial agent. § The tube containing the lowest concentration of the drug that fails to show growth, on subculture, is the MBC of the drug for that test strain. § Broth dilution test can also be done using microtiter plates – micro broth dilution method.

§ For confirming the AST results obtained by disc diffusion tests. § For testing antimicrobial sensitivities of o slow growing bacteria such as tubercle bacilli. o bacteria for which diffusion test is not standardized § When a very small degree of resistance has to be demonstrated. § When therapeutic dose of the drug has to be regulated accurately as in the treatment of bacterial endocarditis.

§ Serial dilutions of the drug are prepared in molten agar and poured into petri dishes. § Test strain is spot inoculated. § Advantages over broth dilution o Several strains can to be tested at the same time by using the same plate o Directly measures the MBC; there is no need of sub culturing as it is done with broth dilution method.

• Uses an absorbent strip containing predefined gradient (serial dilution) of antibiotic concentration immobilized along its length. § Applied to a lawn inoculum. § Antibiotic concentration at which the ellipse edge intersects the strip, is taken as MIC value

§ Automated systems are available: o VITEK 2 identification and antimicrobial sensitivity system (bio. Merieux). o Phoenix System (Becton Dickinson) o Micro Scan Walk Away system § Principle - Micro broth dilution.

- Slides: 79